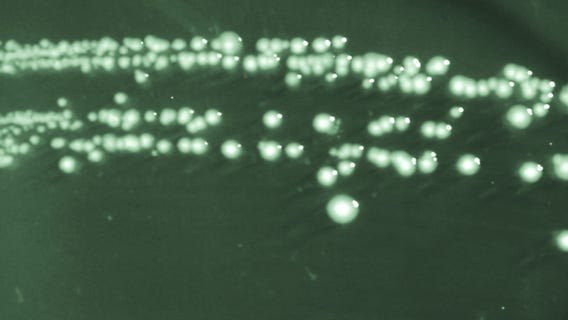
CDC flags increase in stomach bug that’s becoming 'extensively drug-resistant'

In-N-Out has 2nd-healthiest cheeseburger
California-based In-N-Out Burger ranked second among America's healthiest fast-food burger chains, according to a study based on data from Gambling.com.
Florida man dies after contracting brain-eating infection from rinsing sinuses with tap water
The local health department said infection is rare and can only happen when water contaminated with the amoeba enters through the nose.
Colorectal cancer is showing up in younger people and at more advanced stages: study
Doctors are seeing more cases of this form of cancer among those younger than 55 years old.
Ed Sheeran’s wife diagnosed with tumor during pregnancy: ‘Spiraling through depression’
Sheeran and wife Cherry Seaborn welcomed second child in May 2022.
11 minute 'brisk' walks every day could reduce early deaths, study finds
Doing 75 minutes a week of moderate-intensity activity could reduce 1 in 10 early deaths, 1 in 20 cardiovascular disease diagnoses and nearly 1 in 30 cancer cases.
Former NFL cornerback Irv Cross posthumously diagnosed with ‘most severe type’ of CTE, researchers say
Irv Cross, who died in 2012, was diagnosed with Stage 4 CTE.
China dismisses FBI claims on COVID-19 lab-leak theory
FBI Director Christopher Wray said "the FBI has for quite some time now assessed that the origins of the pandemic are most likely a potential lab incident."
LA County to lift COVID emergency declarations on March 31
The LA County board's decision came on the day the statewide COVID emergency declaration ended.
California's COVID-19 state of emergency comes to an end
The end of California’s order will have little to no effect on most people as Newsom has already lifted most of the state’s restrictions.
California's COVID-19 State of Emergency comes to an end
The end of California?s order will have little to no effect on most people as Newsom has already lifted most of the state?s restrictions.
China says it's been 'open and transparent' in search for COVID origins
China said it has been “open and transparent” in the search for the origins of COVID-19, after questions about how the pandemic began received new attention.
Thieves steal cancer patient supplies, wigs from San Mateo bus
A Bay Area non-profit said thieves have stolen a bus that carries supplies to cancer patients. The bus has been recovered. But it's damaged, and almost everything inside was stolen.
Study: Zero-calorie sweetener associated with high risk of heart failure, stroke and death
Researchers also noted that erythritol appeared to cause blood clots more readily in animal testing.
American teens' mental health crisis: What's driving this?
A recent CDC report highlights what mental health experts have been ringing the alarm over: Teens, and specifically girls, are suffering.
Another US agency assesses COVID-19 origin likely a Chinese 'lab leak': report
The Energy Department has reportedly joined the FBI’s stance that the coronavirus likely spread due to a mishap at a Chinese laboratory.
CDC flags increase in stomach bug that’s becoming 'extensively drug-resistant'
It’s called shigellosis, and comes from easily-spread bacteria that are proving to be more and more resistant to antibiotics.
Hiker collapses, dies at Arches National Park
Park rangers said the victim was a 71-year-old man from Massachusetts who was with his wife and son.
FDA approves combination flu-COVID test for home use
This is the first home test for the flu.
California bill would eventually ban all tobacco sales
Some California lawmakers want to eventually ban all tobacco sales, filing legislation to make it illegal to sell cigarettes and other products to anyone born after Jan. 1, 2007.
Bird flu kills 11-year-old girl in Cambodia
Symptoms of H5N1 infection are similar to that of other flus, including cough, aches, fever and, in some cases, life-threatening pneumonia.